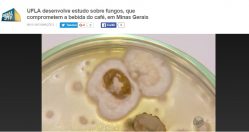

Atenção! Você está acessando um arquivo automático de notícias e o seu conteúdo pode estar desconfigurado. Acesse as notícias mais antigas (anteriores a Maio/2018) em nosso repositório de notícias no endereço www.ufla.br/dcom.
UFLA na Mídia: pesquisa sobre fungos é abordada no Jornal da EPTV
Matéria exibida no Jornal da EPTV Sul de Minas[/caption]
O Departamento de Ciências dos Alimentos da Universidade Federal de Lavras (DCA/UFLA) vem estudando, nas lavouras de café de Minas Gerais, a presença da ocratoxina A, produzida pelo fungo Aspergillus.
O professor Luiz Roberto Batista (DCA/UFLA) explica que é possível identificar o fungo a olho nu, mas no campo, durante a produção agrícola, dificilmente ele será observado. “Durante a secagem o produtor tem que tomar cuidado, para não formar camadas muito altas do café. Não deixar o café amontoado, por muito tempo. E também evitar o uso do café de varrição, em que há a maior concentração de toxinas”, afirmou ao Jornal da EPTV.
De acordo com a professora Rosemary Gualberto (DCA/UFLA), tutora do Núcleo de Estudos em Qualidade, Industrialização e Consumo de Café (QICafé), a presença dos fungos pode estar relacionada a adulteração dos grãos. “A maioria delas ocorre pela inclusão de cascas de café, elementos de outros produtos vegetais. Esses resíduos ficam muito mais expostos às condições que propiciam o crescimento desses fungos”.
Clique aqui para assistir a matéria completa
Matéria exibida no Jornal da EPTV Sul de Minas[/caption]
O Departamento de Ciências dos Alimentos da Universidade Federal de Lavras (DCA/UFLA) vem estudando, nas lavouras de café de Minas Gerais, a presença da ocratoxina A, produzida pelo fungo Aspergillus.
O professor Luiz Roberto Batista (DCA/UFLA) explica que é possível identificar o fungo a olho nu, mas no campo, durante a produção agrícola, dificilmente ele será observado. “Durante a secagem o produtor tem que tomar cuidado, para não formar camadas muito altas do café. Não deixar o café amontoado, por muito tempo. E também evitar o uso do café de varrição, em que há a maior concentração de toxinas”, afirmou ao Jornal da EPTV.
De acordo com a professora Rosemary Gualberto (DCA/UFLA), tutora do Núcleo de Estudos em Qualidade, Industrialização e Consumo de Café (QICafé), a presença dos fungos pode estar relacionada a adulteração dos grãos. “A maioria delas ocorre pela inclusão de cascas de café, elementos de outros produtos vegetais. Esses resíduos ficam muito mais expostos às condições que propiciam o crescimento desses fungos”.
Clique aqui para assistir a matéria completa
Atenção! As notícias mais antigas (anteriores a Maio/2018) estão disponíveis em nosso repositório de notícias no endereço www.ufla.br/dcom.



